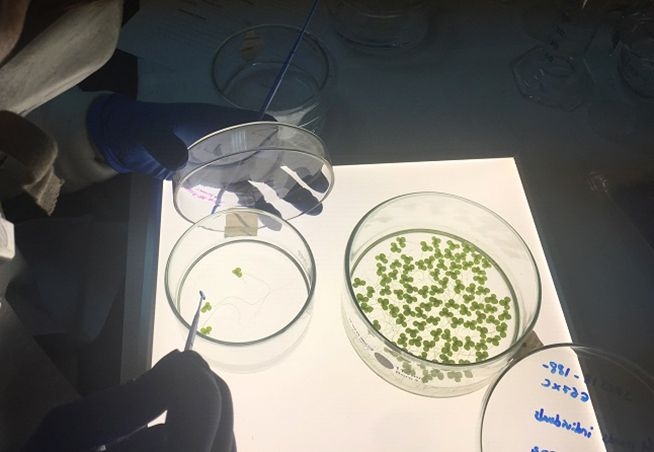

- Laboratorio de Reproducción, Biología del Desarrollo y Ecotoxicología
- Laboratorio de Entomología
- Laboratorio de Invertebrados Acuáticos
- Laboratorio de Biodiversidad y Ecología en Áreas Marinas Someras
- Laboratorio de Ecología de Invertebrados Acuáticos Continentales
- Laboratorio de Fisiología de la Reproducción
- Laboratorio de Biología de Anélidos Poliquetos
- Laboratorio de Ecología
- Laboratorio de Sistemática Molecular y Filogeografía
- Colección Científica del Laboratorio de Biología y Sistemática de Invertebrados Marinos
- Laboratorio de Sistemática y Ecología de Vertebrados
- Laboratorio de Biología y Sistemática de Invertebrados Marinos
- Laboratorio de Zoología de Invertebrados
- Laboratorio de Ecología Integrativa
- Laboratorio de Entomología Médica & Veterinaria "Dr. Fortunato Blancas Sánchez (1919-1988)"
Laboratorio de Reproducción, Biología del Desarrollo y Ecotoxicología
En el laboratorio se han establecido áreas de investigación como: unidad de ecotoxicología acuática, unidad de biología molecular, unidad de histología e histoquímica y unidad de embriología experimental in vitro e in vivo.
En el laboratorio se estudia principalmente:
- El ciclo de reproducción y escala de madurez sexual de organismos acuáticos o terrestres de interés económico y/o ecológico.
- El efecto de plantas medicinales utilizadas en el Perú como reguladores de la fertilidad, como abortivo proandrogénico o anticonceptivo, teniendo como modelo el modelo murino (Mus musculus).
- Embriotoxicología experimental en invertebrados centinelas y en embriones preimplantacionales de ratón.
- El Efecto de nanopartículas de dióxido de titanio y óxido de Zinc en el desarrollo somático de la pulga de agua (Daphnia sp).
Desarrollamos los siguientes protocolos: Espermatograma en ratones, Test de Micronúcleos, Ensayo Cometa, Fragmentación del ADN en Espermatozoides humanos y en ratón, Histología e Histoquímica, Extracción de ADN y ARN y Medición de actividad enzimática (CAT y SOD).
Responsables: Mag. Betty E. Shiga Oshige | Blgo. José Luis R. Pino Gaviño
Miembros: Jacquelyne Zarria Romero, María Fernanda Moyano Arocutipa, Geiro Reisser Camarena Aliaga, Leonardo David Cárdenas Angulo, Joselyn Beatriz Dionisio Zúñiga, Estefani Yojaira Ore Acevedo, Celeste Glacy Huamán Córdova, Gabriela Faaresh Cazorla Cazorla, Gabriel Alexander Revilla Chirinos, Anthony Junior Calle Calderón, Diana Bernaola Medina, Melissa Ysabel Huertas Chambilla, Mery Angie Rivas Yopan, Marvel Yone Palacios Escobar, Valeria Dorila Saavedra Príncipe.

Celular: +51 1 619700 ext. 1529 | +51 945603579 | +51 992169186
E-mail: bshigao@unmsm.edu.pe | jpinog@unmsm.edu.pe
Laboratorio de Entomología
Trabaja en el desarrollo de investigaciones relacionadas con ecología de insectos de bosques de Polylepis, ecología trófica en dieta de reptiles, entomología forense y diversidad de insectos de diferentes órdenes. Además, participan en los eventos organizados por el CERSEU donde exponen sus conocimientos en el desarrollo de proyectos de investigación a los distintos colegios que nos visitan.
Responsable: Eliana del Pilar Quispitupac Quispitupac
Miembros: Mabel Alvarado Gutiérrez

Celular: 964139447
E-mail: equispitupacq@unmsm.edu.pe
Laboratorio de Invertebrados Acuáticos
El laboratorio está implementado para docencia e investigación en el área de zoología, específicamente en la línea de investigación de Biodiversidad y Ecología de Ecosistemas Acuáticos. En este ambiente se desarrollan investigaciones sobre taxonomía, ecología y bioindicación de calidad de agua usando como material biológico los invertebrados dulceacuícolas. El laboratorio apoya los cursos de Diversidad Animal y Macrobentos de Agua dulce, recibe estudiantes interesados en desarrollar su trabajo de investigación para obtención de título profesional y grados académicos.
Cuenta con computador de escritorio, microscopios y estereoscopios de alta resolución con cámara incorporada y equipos para medir parámetros fisicoquímicos del agua en campo.
Responsable: Ana Asunción Huamantinco Araujo
Miembros: Mg. Jorge Peralta Argomeda (profesor auxiliar), Edwin Raúl Vega Raymondi y Jimena Huamaní Bullón (Tesistas).

Celular: 992820057
E-mail: ahuamantincoa1@unmsm.edu.pe
Laboratorio de Biodiversidad y Ecología en Áreas Marinas Someras
Sus actividades están dedicadas a comprender la biodiversidad de los ambientes marinos intermareales y las áreas marinas someras en Perú. Nuestra investigación taxonómica se esfuerza por documentar la diversidad de invertebrados que habitan la costa peruana, avanzando así en el conocimiento de la biodiversidad marina y apoyando nuestra colección científica de invertebrados marinos. El laboratorio ha contribuido activamente al proyecto NaGISA, un componente del Censo de la Vida Marina, y actualmente participa en evaluaciones continuas de costas rocosas en cuatro ubicaciones a lo largo de la costa peruana como parte de la iniciativa regional SARCE (Grupo de Investigación Sudamericano en Ecosistemas Costeros).
El laboratorio también acoge a estudiantes interesados en realizar investigaciones para sus tesis, con un enfoque en taxonomía de invertebrados, ecología de poblaciones, ecología del comportamiento, historia de vida o morfología.
Además, el laboratorio ofrece servicios para el análisis de muestras bentónicas marinas y la identificación taxonómica de algas e invertebrados marinos, particularmente gusanos poliquetos, pequeños crustáceos, equinodermos y otros grupos menores. Todo el equipo y material necesario para la recolección de muestras y el análisis de laboratorio están disponibles.
Responsable: Leonardo Romero Chumpitaz

Celular: 943984435
E-mail: lromeroc@unmsm.edu.pe
Laboratorio de Ecología de Invertebrados Acuáticos Continentales
Tiene como líneas de investigación el estudio de la biodiversidad de invertebrados en ambientes acuáticos continentales y los procesos ecológicos que influyen en su distribución, contribuyendo en el desarrollo e implementación de herramientas de bioindicación que permitan un diagnóstico eficaz de la calidad del ecosistema dulceacuícola. Así mismo, fomenta el desarrollo de capacidades en investigación de los estudiantes y tesistas de pre y posgrado promoviendo la publicación y difusión del conocimiento en medios científicos.
El laboratorio se encuentra asociado al grupo de investigación Biodiversidad y Ecología de Ambientes Acuáticos Continentales (BIOAQUA), esto permite sumar esfuerzos para generar información que sirva a la conservación y manejo sostenible de los ambientes acuáticos; además, de mantener una colección científica de referencia y representativa de invertebrados dulceacuícolas de nuestro país.
Los principales proyectos de investigación que se han desarrollado hasta la fecha son los siguientes: Determinación de los valores de bioindicación a contaminación para la entomofauna acuática en humedales costeros del Perú y Diversidad y distribución geográfica de Macroinvertebrados acuáticos en los humedales costeros de Perú.
Responsable: M. Sc. Jorge Luis Peralta Argomeda
Miembros: Dra. Ana Huamantinco Araujo

Celular: 995386544
E-mail: jperaltaa@unmsm.edu.pe
Laboratorio de Fisiología de la Reproducción
Nuestro trabajo está dedicado a evaluar la función reproductiva de animales de importancia para nuestro país, las investigaciones están dirigidas a evaluar la función e interacción de gametos, la fecundación y el desarrollo embrionario temprano profundizando aspectos fisiológicos, bioquímicos y moleculares. Se utilizan biotecnologías reproductivas tendientes a mejorar el éxito reproductivo como capacitaciones espermáticas, fecundación in vitro IVF, criopreservación de gametos y embriones).
Actualmente estamos en la búsqueda de marcadores moleculares de fertilidad masculina en alpacas, otra línea de trabajo está dedicada a evaluar el efecto de plantas nativas peruanas promotoras de la fertilidad, así como el efecto de agentes físicos y químicos que puedan influir negativamente sobre la fertilidad masculina o femenina a nivel preclínico y clínico. Y de conservación de gametos con criogenia especialmente con animales de importancia económica, por ejemplo zánganos.
Poseemos una estrecha interacción con investigadores de la Universidad Libre de Bruselas y con cuyos especialistas destacados en el área de la reproducción con los cuales organizamos anualmente el Curso Internacional en esta área, con la finalidad de promover el incremento de capacidades en esta área.
Responsable: Dra. Martha Valdivia Cuya
Miembro: Zezé Bravo Gutiérrez

Celular: (+51) 619 7000 anexo 1541
E-mail: mvaldiviac@unmsm.edu.pe
Laboratorio de Biología de Anélidos Poliquetos
Como parte de las investigaciones sobre la biodiversidad en áreas marinas costeras que desarrolla el ICBAR, este Laboratorio realiza estudios dirigidos a incrementar el conocimiento sobre la distribución de la fauna de anélidos poliquetos y su importancia.
Estos estudios incluyen la descripción taxonómica y la estimación de la abundancia relativa de las especies halladas durante los muestreos cualitativos y cuantitativos en algunas bahías como las de Ancón y Chorrillos.
Responsable: Mg. Elba Canahuire Cairo

Laboratorio de Ecología
El Laboratorio de Ecología realiza investigaciones en el ámbito del perfil submareal marino somero. Desarrollamos diversos trabajos que incluyen estudios auto ecológicos, análisis de poblaciones, análisis de comunidades, así como conocer patrones biogeográficos en el espectro de nuestra costa peruana.
Nos interesa conocer la dinámica poblacional de especies de importancia económica como ecológica y de esa forma determinar el rol que cumplen en el estrato en que se desenvuelven, tratando de establecer su papel en una serie de tiempo.
En la parte comunitaria se investiga la diversidad en diferentes tipos de sustratos, incluyendo fondos con un determinado perfil de suelo o de mezcla, rizoides de macro algas; de esta forma determinar el rol que juega este último medio físico en la variabilidad de la diversidad dependiendo de su ubicación tanto en un perfil latitudinal y de profundidad. Para tal fin contamos con microscopios estereoscópicos, microscopio compuesto, balanza analítica de precisión, estufa, entre otros equipos básicos. Por otro lado, contamos con Unidades de Procesamiento de Datos (PCs) usando los programas compatibles para el análisis de los resultados.
Responsable: Blgo. Oswaldo Benjamín Cornejo González

Laboratorio de Sistemática Molecular y Filogeografía
Nuestra investigación se enfoca en el uso de datos de genética molecular (secuencias de DNA) para el entendimiento del origen y diversidad biológica. Usamos como modelo a moluscos continentales. Adicionalmente estamos desarrollando estudios en evolución de plantas, en especial palmeras, liderados por el Dr. Pintaud. Este enfoque molecular va de la mano con el análisis morfológico y biogeográfico, desarrollado en colaboración con el Museo de Historia Natural de la UNMSM.
Responsable: Dra. Rina Lastenia Ramírez Mesías

Colección Científica del Laboratorio de Biología y Sistemática de Invertebrados Marinos
Responsable: Blgo. Franz Teodosio Cardoso Pacheco

Laboratorio de Sistemática y Ecología de Vertebrados
Responsable: Dr. César Augusto Aguilar Puntriano

Laboratorio de Biología y Sistemática de Invertebrados Marinos
En el laboratorio se realizan investigaciones sobre la biología, sistemática, taxonomía y ecología de los invertebrados marinos celomados, especialmente de los moluscos, los crustáceos, poliquetos y equinodermos. Los temas principales son el inventario de la biodiversidad y la actualización de la nomenclatura, la misma que cambia permanentemente, debido a que con las nuevas metodologías se están redefiniendo las relaciones filogenéticas de las especies.
El Laboratorio tiene relaciones con especialistas malacólogos del Santa Barbara Museum of Natural History, USA; el Department of Zoology, University of British Columbia, 6270 University Boulevard, Vancouver, B.C., Canada; y el A.V. Zhirmunsky Institute of Marine Biology of the Far Eastern Branch of the Russian Academy of Sciences, Russia.
Los resultados permitirán constituir colecciones de referencia y elaborar catálogos ilustrados. También se hacen estudios sobre comensalismo, formas de reproducción, comunidades del intermareal rocoso, macroinvertebrados asociados a las algas del infralitoral, y se han iniciado estudios de biología molecular en cefalópodos. Acerca de las investigaciones en moluscos, se trabaja en colaboración con el Instituto del Mar del Perú (IMARPE).
Responsable: Blgo. Franz Teodosio Cardoso Pacheco

Laboratorio de Zoología de Invertebrados
En el Laboratorio se realizan actividades relacionadas a la taxonomía, distribución y biodiversidad de los protozoos e invertebrados acelomados y pseudocelomados. Este trabajo requiere del acopio de información específica de cada uno de estos Taxa en sus diversos aspectos, que son la base para realizar las actividades de docencia, investigación y proyección social. Para el cumplimiento cabal de todo ello se ha implementado en el laboratorio, una infraestructura adecuada, equipos y reactivos específicos, así mismo se emplean métodos y protocolos según el Taxa y el aspecto en estudio.
Los resultados de los trabajos de investigación son publicados periódicamente en revistas especializadas; de esta manera se contribuye al conocimiento de los diversos taxa mencionados, enriqueciendo la información para el país y la comunidad científica, a la vez que constituyen la base para el cambio continuo de los enfoques y modelos de enseñanza-aprendizaje.
Responsable: Blgo. Ruperto Severino López

Laboratorio de Ecología Integrativa
Responsable: Dr. José Miguel Pérez Zuñiga

Laboratorio de Entomología Médica & Veterinaria "Dr. Fortunato Blancas Sánchez (1919-1988)"
El Laboratorio de Entomología Médica y Veterinaria realiza estudios y vigilancia de insectos y arácnidos que podrían poner en riesgo la salud de las personas y de sus mascotas.
Monitorea poblaciones de insectos vectores de enfermedades y de otros artrópodos de importancia médica y veterinaria. Tiene un equipo capacitado para acudir al llamado de los usuarios, a fin de atender una emergencia por presencia de éstos, observados en domicilio o en el peri-domicilio, los mismos que puedan estar causando fobias, perturbando la tranquilidad de las personas. Recepciona muestras de insectos o de otros artrópodos colectados por los usuarios, a fin de realizar la correspondiente identificación e informe del potencial riesgo que estos significan para la salud de las personas y /o mascotas. También prepara materiales de estudio (Insectos y otros artrópodos de importancia médica y veterinaria) a fin de contar con el adecuado material para docencia y/o exposición científica.
Responsable: Blga. Alicia Encarnación Diestro Diestro

Celular: (+51) 619 7000 anexo 1540
E-mail: adiestrod@unmsm.edu.pe